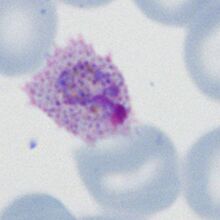

Comet form 1
From MalariaETC
| Navigation |
| >Previous Page |
| "Comet" late trophozoite of P.ovale
The combination of ovoid shape that is typical of P.ovale and the fimbriation of the erythrocyte cytoplam (often at one or both poles of the elongated shape) gives some parasites in this species a characteristiic shape often referred to as a "comet" (see the image below). |